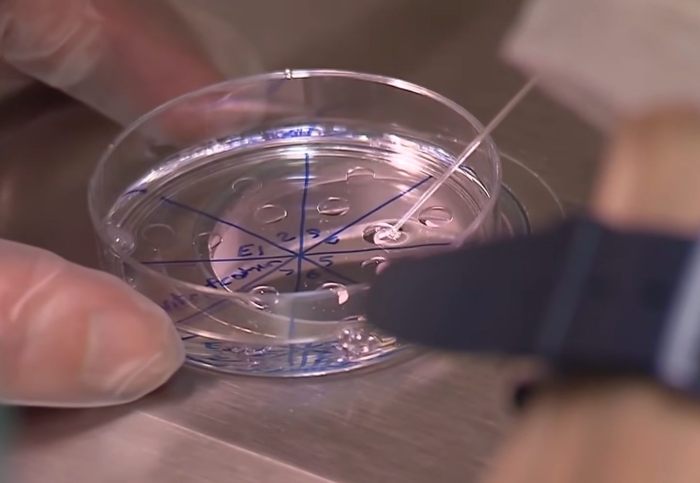
Casal processando clínica de fertilidade por confusão de fertilização in vitro finalmente identifica os pais biológicos do bebê

🤯 INCRÍVEL: Couple Suing Fertility Clinic Over IVF Mix-Up Finally ID Baby’s Biological Parents 😲
O casal que processou sua clínica de fertilização in vitro por implantar o embrião errado compartilhou uma atualização sobre o bebê pais biológicos.
Em janeiro, Tiffany Score e Steven Mills entraram com uma ação judicial contra o Fertility Center de Orlando, que anunciou recentemente que fecharia suas portas.
O casal teria produzido e armazenado três embriões viáveis na clínica de fertilização in vitro. Em 11 de dezembro de 2025, eles deram as boas-vindas a uma menina saudável chamada Shea.
- Tiffany Score e Steven Mills processaram o Centro de Fertilidade de Orlando em janeiro, alegando que implantaram o embrião errado.
- Os testes de DNA identificaram os pais biológicos de Shea, mas Score e Mills não revelarão seus nomes para manter sua privacidade.
- O Centro de Fertilidade de Orlando, localizado na Flórida Central, anunciou seu fechamento em meio ao processo.
Uma confusão de fertilização in vitro transformou o sonho de Tiffany Score e Steven Mills em um pesadelo jurídico

Créditos da imagem: WESH
Mas os pais perceberam que houve uma confusão quando Shea “exibiam a aparência física de uma criança racialmente não caucasiana”, apesar de serem caucasianos, afirmou o processo.
Score e Mills disseram que amam sua filha de 4 meses “mais do que as palavras podem expressar”, mas ainda sentem que têm “a obrigação moral de encontrar seus pais genéticos”.
Em comunicado compartilhado com Pessoas revista na quarta-feira (22 de abril), o casal confirmou que finalmente encontrou os pais biológicos de Shea.
Créditos da imagem: WESH
“Os resultados dos testes que nos foram entregues hoje confirmam que os pais genéticos do nosso bebé foram identificados”, disseram.
Score e Mills planejam manter “confidencial” a identidade dos pais biológicos de seu bebê, observando que “pretendem cooperar totalmente no respeito à sua privacidade”.
Identificando a genética de Shea paisdisseram eles, reacende as preocupações sobre o que o Centro de Fertilidade de Orlando fez com seu próprio material genético.
“Isto encerra um capítulo da nossa dolorosa jornada, mas levanta novas questões que terão de ser resolvidas”, disseram Score e Mills. “Além disso, as questões sobre a disposição dos nossos próprios embriões ainda estão sem resposta e é ainda mais improvável que alguma vez sejam respondidas.”
Depois de dar as boas-vindas à sua filha, Shea, Score e Mills confirmaram que ela não era biologicamente deles e processaram a clínica de fertilização in vitro
Créditos da imagem: Canal 9 da WFTV
O advogado deles, Jack Scarola, disse Pessoas que “as questões restantes sobre o destino dos embriões desaparecidos de Tiffany e Steven… ainda estão pendentes”.
Segundo o advogado, o casal espera que o processo judicial dê essas respostas e também ofereça uma compensação “pelas despesas em que incorreram e pelo grave trauma emocional que suportaram e continuarão a sofrer”.
Embora o casal tenha expressado medo sobre a possibilidade de os pais biológicos de Shea a tirarem deles, Scarola confirmou que os pais genéticos não fizeram essa exigência.
Créditos da imagem: Pixabay/SeppH (não a foto real)
Com o processo contra a clínica de fertilidade, Score e Mills esperam “começar a viver mais livremente e finalmente celebrar a única coisa linda que resultou de tudo isto: a nossa filha”.
Os orgulhosos pais disseram que bebezinha “é completamente inocente e tão indigno” do alegado erro médico da clínica.
“Apenas uma coisa é tão absolutamente certa hoje como era no dia em que nossa filha nasceu: amaremos e seremos os pais dessa criança para sempre”, acrescentaram Score e Mills sobre Shea.
O casal ainda aguarda respostas sobre o destino de seus embriões

Créditos da imagem: WESH
Depois que Shea nasceu, o casal recorreu Teste de DNA e supostamente confirmou que ela não era biologicamente relacionada a nenhum deles.
“Embora estejamos muito gratos por tê-la em nossas vidas e amá-la imensamente (…) estamos com o coração partido, devastados e confusos”, declararam os pais em janeiro, após entrarem com a ação judicial.
Em sua declaração, Score e Mills acrescentaram que decidiram se manifestar em parte para evitar “rumores prejudiciais ou desinformação” sobre a gravidez.
Créditos da imagem: WESH
“De igual preocupação para os Requerentes é a possibilidade óbvia de que alguém tenha recebido um ou mais de seus embriões implantados e esteja grávida ou tenha estado grávida e esteja atualmente cuidando de um ou mais de seus filhos”, diz o processo, conforme WFLA.
Score e Mills estão pedindo que a clínica de fertilização in vitro forneça testes genéticos gratuitos para todos os seus pacientes dos últimos cinco anos e os informe sobre quaisquer discrepâncias encontradas durante os testes.
A ação também solicita que a clínica com sede em Longwood notifique imediatamente todos os pacientes que tinham embriões armazenados antes da implantação do Score sobre as alegações da denúncia.
Score e Mills estão pedindo à clínica de fertilização in vitro que ofereça testes genéticos gratuitos a todos os pacientes dos últimos cinco anos
Créditos da imagem: WESH
Além da clínica, Milton McNichol, seu fundador e endocrinologista reprodutivo chefe, também é citado como réu no caso.
TO Centro de Fertilidade de Orlando nunca negou a possibilidade de erro.
Num comunicado de janeiro, a clínica disse que estava “cooperando ativamente com uma investigação para apoiar um de nossos pacientes na determinação da origem de um erro que resultou no nascimento de uma criança que não é geneticamente relacionada a eles”.
O centro explicou que estava a trabalhar para identificar quando e onde o erro pode ter ocorrido e que estava a cooperar ativamente com a investigação em curso.
Créditos da imagem: WESH
Este mês, o Centro de Fertilidade de Orlando anunciou que fecharia e que outra clínica seria inaugurada no mesmo local. TO anúncio no site da clínica não especificou por que ela estava fechando ou se o Dr. Milton McNichol continuaria trabalhando lá.
As ações judiciais seguem problemas financeiros para a clínica de fertilização in vitro, que entrou com pedido de falência, Capítulo 11, no final de 2024, conforme Notícias da NBC.
Nos Estados Unidos, aproximadamente 100.000 bebês nascem a cada ano através de fertilização in vitro
Créditos da imagem: Linha noturna
O centro teria sido citado por violações pelo Departamento de Saúde da Flórida em 2023, depois que uma inspeção de rotina revelou vários problemas, incluindo equipamentos que não atendiam aos padrões de desempenho atualizados e falta de lidocaína nas instalações, um medicamento que pode ser usado para tratar parada cardíaca.
Nos Estados Unidos, cerca de 100 mil bebês nascem anualmente através de FIV (fertilização in vitro) tecnologia; no entanto, a indústria continua em grande parte não regulamentada no país, sem bases de dados fiáveis que rastreiem erros em clínicas nacionais de fertilização in vitro disponíveis para potenciais pacientes.
Obrigado! Confira os resultados:
Total de votos ·
📢 Gostou da notícia? Compartilhe com os amigos!
Este artigo é uma tradução automática de uma fonte original. Para ler o conteúdo na íntegra: Clique aqui.




